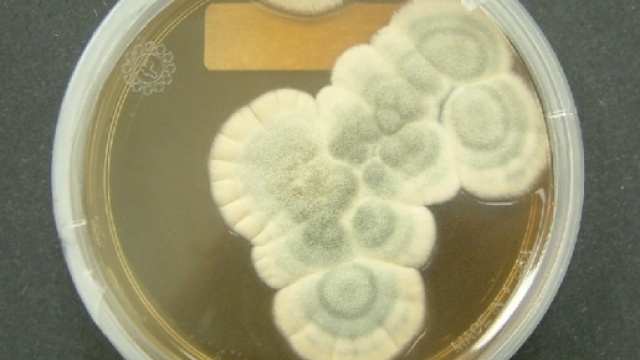
Le batterie esauste di smarphone e tablet potrebbero essere riciclate con l'aiuto di tre tipi di fungo

Grazie ai funghi, le batterie di tablet e smartphone potrebbero essere riciclabili: questa è la chiave per il possibile recupero dei metalli agli ioni di litio delle batterie esauste, onnipresenti sui moderni dispositivi elettronici. Purtroppo sono altamenteinquinanti, quindi, per salvaguardare la salute e l'ambiente è importantissimo pensare al loro smaltimento: infatti, negli inceneritori e in discarica ne finiscono a milioni, creando quindi emissioni molto nocive.
Funghi per il recupero delle batterie esauste
Si tratta di prodotti a lunga durata che, dopo un certo numero di 'carica e scarica', iniziano a perdere la loro potenza fino a esaurirsi completamente.
Un gruppo di ricercatori ha però dimostrato (in uno studio fatto dalla 'University of South Florida') che l'uso di tre funghi combinati insieme - come il Penicillium simplicissimum, l'Aspergillus niger e il Penicillium chrysogenum - permette di estrarre litio e cobalto dalle batterie, con gran risparmio delle industrie produttrici: 'L'idea parte da uno studente - spiega Jeffrey A. Cunningham, a capo della ricerca - è riuscito, per la prima volta, a estrarre alcuni tipi di metalli dai residui rimasti dopo alcune operazioni di fusione. L'uso degli smartphone e altri prodotti alimentati con batterie ricaricabili è in costante crescita; quindi, la nostra attenzione si è spostata in tal senso. Non è più sostenibile continuare con l'estrazione di nuove risorse; tuttavia, la richiesta di litio è in enorme aumento, ecco il perché della nostra ricerca'.
Un modo sostenibile e sicuro per il recupero delle batterie
Per separare il cobalto, il litio e altri metalli esistono altri metodi, ma richiedono l'uso di prodotti corrosivi e temperature molto alte. Il team di Jeffrey A.Cunningham sta cercando la soluzione più sicura e 'pulita', sviluppando un modo sostenibile per il recupero delle batterie esauste: in pratica, dopo averle smantellate, i catodi vengono polverizzati e poi il tutto è esposto ai funghi; questi in seguito generano acidi organici che permettono di estrarre i metalli: 'Puntiamo al recupero - aggiunge il ricercatore - di quasi tutto il materiale utile'.
Durante il corso dello studio i risultati ottenuti sono stati notevoli: si riescono a estrarre, con l'uso dei funghi, fino al 48% del cobalto e addirittura l'85% del litio, dai catodi delle batterie ormai esauste; per l'estrazione dei metalli, invece, non si è rivelato efficace l'acido gluconico. Al momento il team dei ricercatori è impegnato a capire come mai, dopo aver esposto ai funghi il litio e il cobalto, tali elementi rimangono in ambiente liquidoe come estrarli.